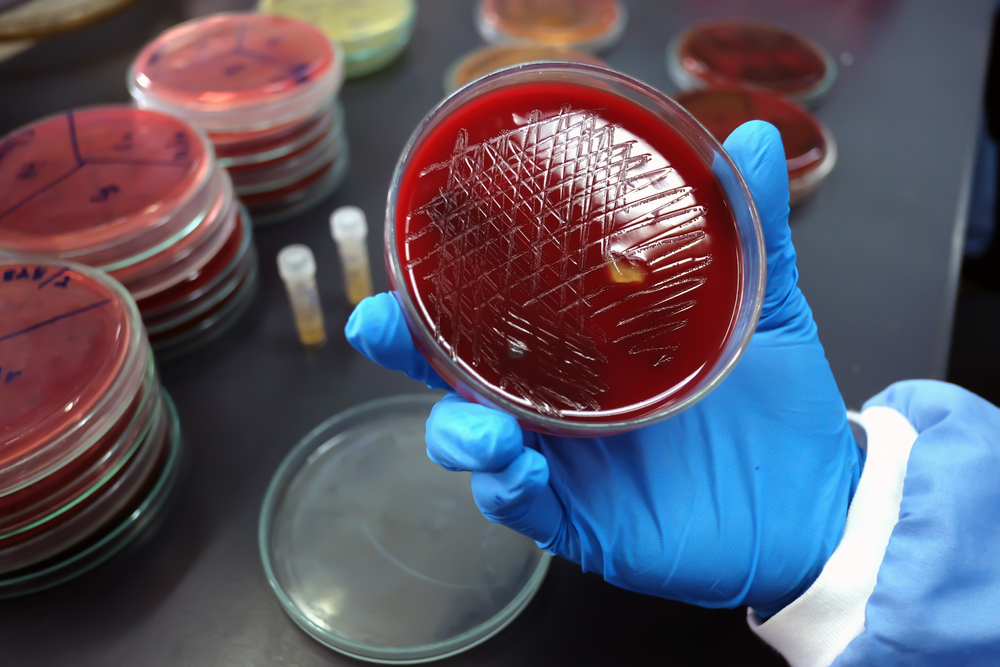

What is Pathology Tests Explained?
Pathology Tests Explained (PTEx) is a not-for profit group managed by a consortium of Australasian medical and scientific organisations.
With up-to-date, evidence-based information about pathology tests it is a leading trusted source for consumers.
Information is prepared and reviewed by practising pathologists and scientists and is entirely free of any commercial influence.